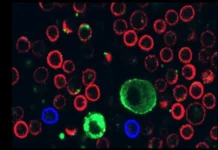
Кармит Леви рассказала об открытии влияния везикул меланомы на иммунные клетки в Тель-Авивском университете karmit levi rasskazala ob otkrytii vliyaniya vezikul melanomy na immunnye kletki v telavivskom universitete-ekbonline-ru-0

Ученые института раскрыли уникальные защитные механизмы, предохраняющие нервные клетки от губительного воздействия мутантных белков, провоцирующих боковой амиотрофический склероз (БАС). Это прогрессирующая нейродегенеративная болезнь, поразившая, в частности, великого астрофизика Стивена Хокинга.
"Наше исследование указывает: изменения в активности определенных генов способны противостоять опасным изменениям, вызванным мутантными версиями белка FUS в нейронах. Углубленное изучение этих компенсаторных механизмов открывает перспективу создания методов, активирующих внутренние защитные ресурсы нервной системы для борьбы с БАС", – объясняет Наталья Нинкина, профессор ИФАВ РАН (Черноголовка), соавтор исследования.
БАС: вызов науке и надежда на прорыв
Боковой амиотрофический склероз – тяжелое заболевание ЦНС, ведущее к параличу и мышечной атрофии. Существующая терапия лишь незначительно замедляет его ход, а точные причины развития остаются неясными.
Прогноз часто неутешителен, но истории некоторых пациентов, таких как Стивен Хокинг или гитарист Джейсон Беккер, вселяют уверенность. Их уникальный случай резкого торможения болезни (Хокинг прожил с ней более пятидесяти лет!) доказывает, что поиск защитных механизмов у человека имеет под собой реальную основу.
Ключевой игрок: таинственный белок FUS
Команда Натальи Нинкиной сосредоточилась на понимании роли мутаций в белке FUS, который является ключевым фактором наследственных форм БАС.
В здоровых нейронах FUS стабильно находится в ядре клетки. Однако при развитии БАС он начинает перемещаться за пределы ядра, образуя токсичные скопления – белковые агрегаты, что вызывает масштабную гибель двигательных и других нервных клеток.
Эксперимент: моделирование БАС на мышах
Для изучения этого процесса исследователи создали две линии генетически модифицированных мышей, продуцирующих человеческий белок FUS. Его структуру изменили так, чтобы он активно покидал ядро, что искусственно воспроизводило основной признак БАС – накопление опасного "белкового мусора".
Ключевое отличие между линиями заключалось в количестве вырабатываемого мутантного белка: в одной – нормальный уровень, в другой – пониженный. Ученые внимательно анализировали состояние животных и активность их генов в поисках факторов, влияющих на течение болезни.
Сенсационный результат и защитные силы нейронов
Наблюдения принесли неожиданный результат: мыши с низким уровнем мутантного FUS оставались здоровыми даже в почтенном возрасте, в то время как их сородичи с нормальной экспрессией белка стремительно теряли подвижность. Это навело ученых на мысль о существовании природных защитных систем в нейронах, противодействующих малым дозам поврежденного FUS.
Сравнив активность генов в спинном мозге всех типов мышей (модифицированных и обычных), нейрофизиологи ИФАВ РАН обнаружили масштабные изменения в работе сотен генов, ответственных за межнейронные контакты, функции двигательных нейронов и другие процессы. Это стало прямым свидетельством активации внутренней защиты.
Путь к новой терапии
Сравнительный анализ активности генов показал: открытые защитные механизмы способны распознавать появление дефектных FUS-молекул и нейтрализовывать их угрозу. Дальнейшая идентификация ключевых генов, вовлеченных в этот процесс, представляет собой обнадеживающую перспективу для создания лекарств нового поколения. Цель – предотвращение накопления токсичного белка и остановка разрушения нейронов при БАС.
Источник: scientificrussia.ru